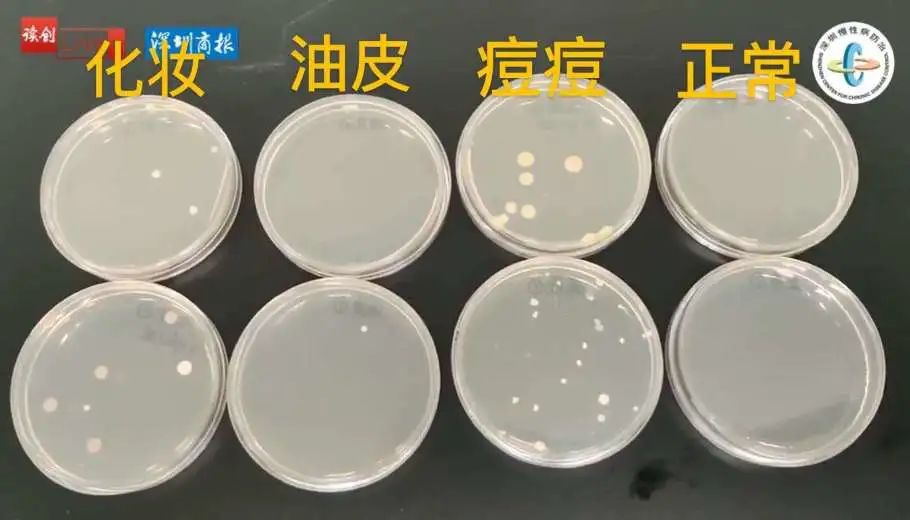

您现在所在的位置 :
电影天堂-电影天堂官方最快发布站 > 汕尾市科学技术局 > 专题 > 科普专栏
随着天气变得又闷又热
口罩又不得不整天戴着
不少朋友们都会渐渐陷入了一种
要脸还是要命的生存危机中
图片来源:网络 白头、泛红、痘痘全部上阵 以往从未试过过敏 这次却成功晋级为 传说中的“口罩脸” “口罩脸”别甩锅口罩 都怪你撸妆! 一摘口罩还是这条gai最靓的女! 医生摇摇头,低声地说了一句: “最近啊,不止一个像你这种口罩脸妹子......” “这几个月来,门诊确实接诊了不少爆痘、皮肤过敏的患者。大多数人都是因为长期戴口罩而出现接触性皮炎、面部皮炎和痤疮。而爆痘的状况,也比以往严重,痘痘大、深、痛、多。” ——深圳市慢性病防治中心皮肤科医生 原来,看到“口罩脸”患者越来越多后,中心的皮肤科医生关杨和郑锦芬做了个实验: #闷了一天的口罩到底有多少细菌?# 结果发现—— 化妆+戴口罩=死亡操作! 培养的细菌仅次于痘痘肌 她们设置了4种情况,分别让志愿者戴了8小时口罩: 素颜 化妆 痘痘肌 油性皮肤 ▽ 这说明啥?说明“口罩脸”不能只找口罩背锅。 还有起码一半的责任,得自己扛—— 只要不化妆,正常佩戴口罩,其实是不会导致很严重的皮肤问题。 但如果化了妆,再长期戴同一个口罩,就哦豁了。 此外,痘痘肌的菌落最多,这意味着,痘痘肌本身就有问题,长期闷口罩可能会让皮肤问题更加严重。 但让医生最意外的是,同样是素颜戴口罩,“大油田”也产生了菌落。 关于这点,还要等医生后续跟踪,查明源头所在。 无论如何,化了妆戴口罩,闷出了一脸痘, 陷入了这个危“肌” 小仙女该怎么拯救拯救? 看到这个结果,有的姐妹可能会想: “既然化妆戴口罩会烂脸,那不戴不就好了?(反正现在疫情也没那么严重了)” 但如果自己还是舍弃不了一颗爱美之心,医生建议: 化妆戴口罩可以 但要注意这几点 已经中招“口罩脸”的 可以这样自救 症状较轻 可以用弱效激素乳膏(如丁酸氢化可的松)擦拭患处; 如果是面部皮炎,出现瘙痒症状,不要搔抓皮肤,应该用温和不刺激的保湿霜,让皮肤屏障功能逐渐修复,慢慢治愈 长痘的妹子要勤换口罩,注意面部清洁,少吃油炸油腻及高脂高糖的食物; 长粉刺的,可以外擦维A酸类凝胶(如阿达帕林凝胶); 如果有丘疹、脓疱、结节,则要用抗生素乳膏。 如果是皮肤过敏,在天气炎热时尽量减少外出,同时使用温和不刺激的保湿润肤霜。 出现皮肤红斑瘙痒的时候,不能搔抓皮肤,否则会加重皮肤炎症,皮损较多。 病情较重 建议到皮肤科就诊。 最后,医生还提醒一句:戴口罩也要做好防晒!

因为这玩意儿虽然能挡住部分阳光,但并不能挡住紫外线中UVA、UVB。
如果“口罩脸”过于严重,无法擦防晒霜,可以遮阳伞开起来,遮阳帽戴起来。
您访问的链接即将离开“汕尾市科技局”网站,是否继续?

粤公网安备 44150202000004号